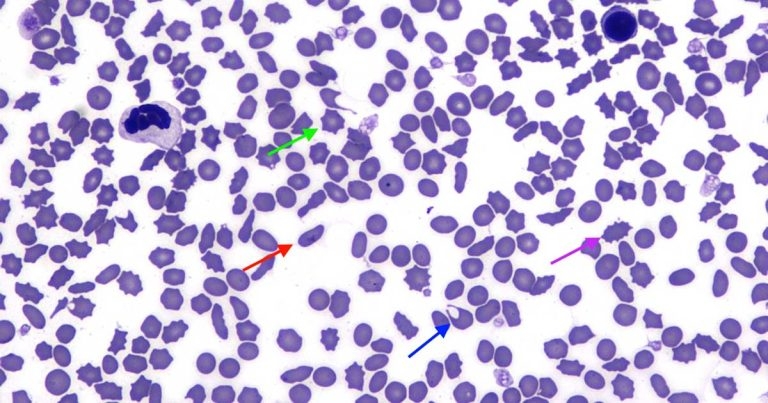
Red cell morphological alterations in a cat with anaemia

7 Oct 2019
Francesco Cian discusses the case of an adult, domestic shorthair cat with clinical history of anappetence, weight loss and lethargy in his latest Haematology Hub column.
Figure 1. The blood smear image.
The image in Figure 1 (Wright-Giemsa 50×) and the haematology data (Table 1) are from an ethylenediaminetetraacetic acid blood sample of an adult, domestic shorthair cat with clinical history of inappetence, weight loss and lethargy.
Evidence of mild normocytic normochromic anaemia is present as haematocrit is mildly decreased, and both mean corpuscular volume and mean corpuscular haemoglobin concentration values are within reference ranges. The low reticulocyte count and the absence of polychromatophils confirm the anaemia is non-regenerative.
Interestingly, on blood smear examination, most red blood cells show marked variation of shapes instead of appearing as biconcave discs. This condition is known as poikilocytosis – from ancient Greek poikilos, which means “varied”.
The diagnostic relevance of poikilocytes is number, shape and context-dependent. For example, low numbers of misshapen red blood cells can be seen in blood samples from clinically normal or ill animals and may not be clinically significant.
Poikilocytosis may be observed in various disorders associated with erythrocyte fragmentation – including disseminated intravascular coagulation, liver disease, myeloid neoplasms, myelofibrosis and renal disease. It can also be observed in dogs with vascular neoplasms and iron deficiency anaemia.
When possible, all the abnormal red blood cell shapes should be distinguished. In this case, we can observe the following abnormalities:

Biochemistry testing on this cat revealed an elevation of liver enzymes, total bilirubin and bile acids. In particular, alkaline phosphatase was markedly increased (1,185U/I; reference range 11U/I to 210U/I) despite a very mild elevation of gamma-glutamyltransferase (7U/I; reference range 0U/I to 4U/I).
In cats, this pattern is often observed in association with hepatic lipidosis. Ultrasound revealed a hyperechoic hepatic parenchyma. Liver aspirates demonstrated the presence of clusters of hepatocytes with abundant foamy cytoplasm, distended by variably sized clear globules, frequently obscuring the nuclear outline; overall, indicative of lipid accumulation (Figure 2).
These cytological findings were considered supportive of hepatic lipidosis.
Hepatic lipidosis occurs most frequently as a consequence of prolonged starvation and/or metabolic diseases that result in marked decrease in appetite. Obese and overweight cats are at increased risk.
According to a retrospective study by Christopher et al (1994), cats with hepatic lipidosis are likely to have poikilocytosis – mainly due to increased blood cell membrane fluidity and deformability secondary to alterations in plasma cholesterol, lipid, electrolytes and vitamin E – that often accompany liver diseases.
Reference